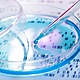
Preimplantation genetic testing at nef

-
In 1937, Dr. John Rock detailed his prediction in the New England Journal of Medicine. He predicted that over time technology would develop allowing people to specifically choose their child with genetic testing.
-
Angell et. al. wrote the first papers evaluating human embryo chromosomes in 1983. They concluded that 2/3 of the embryos tested had chromosomal anomalies that would likely result in embryonic loss when implanted. This helped further research of other types of chromosomal anomalies and the beginning of attempt to count chromosomes.
-
In the 1980s, Alan Handyside developed preimplantation genetic diagnosis (PDG) with the first successful test being completed in 1989 for Cystic Fibrosis, which is an X-linked disease. PDG at the time was used to determine the sex of the embryo in order to give birth to a child without a sex-linked chromosomal disease.
-
Handyside performed a biopsy a year later on embryos three days after fertilization to determine if they would have a genetic mutation. This test demonstrated that it could be determined whether or not an embryo carried a single-gene disease before implantation. Parents are now able to make the decision to hinder passing inherited genetic mutations to their children.
-
In 2008, Nathan Treff validated the platform that uses whole genome amplification to analyze all 24 chromosomes. This has led to improved implantation and live birth rates, as well as decreased miscarriages. As technology and science continue to improve PGD, it will likely become a more viable option for parent going through in vitro fertilization.
-
In recent years PGD has continued to develop to be able to test for more genetic diseases. Over time, safety has improved and costs have been lowered. This makes PGD more accessible and a possible consideration for many parents who are going through the process of in vitro fertilization.
-
While PGD has many benefits of allowing parents to reduce the passing of genetic diseases, there are some ethical questions to be asked. Some argue that PGD goes against nature by specifically choosing on embryo over another. Others believe that the process of in vitro fertilization and PGD is wrong because some embryos that are created will never be carried to term. Still, there is the potential for PGD to be used in the future to determine characteristics not related to health, like eye color.
-
The country is heading towards more controversy with PGD because it is a new and developing process. As it becomes easier to determine characteristics not related to health, some people will likely strongly oppose PGD because it limits genetic diversity.
Over time, the actual process of PGD has changed the most. It has improved with better science and technology. Since this issue is relatively young there has been little perspective shifts. -
There have not been any compromises regarding PGD yet. I anticipate in the future PGD will be regulated only to test for genetic mutations and not characteristics unrelated to health. I predict that there will be much more controversy over this issue as more people utilize it since it has become safer and cheaper.
-
Davidson, M. R. (2018, November 15). Preimplantation genetic diagnosis. Retrieved from https://www.britannica.com/science/preimplantation-genetic-diagnosis Shoham, G. (n.d.). History of PGD and PGS. Retrieved from https://ivf-worldwide.com/cogen/oep/pgd-pgs/history-of-pgd-and-pgs.html The Embryo Project Encyclopedia. (n.d.). Retrieved from https://embryo.asu.edu/pages/preimplantation-genetic-diagnosis
Looking for a timeline maker?
Create timelines for projects, roadmaps, history, lessons, legal cases, and stories with Timetoast. Timetoast is a timeline maker for work, school, research, and stories.